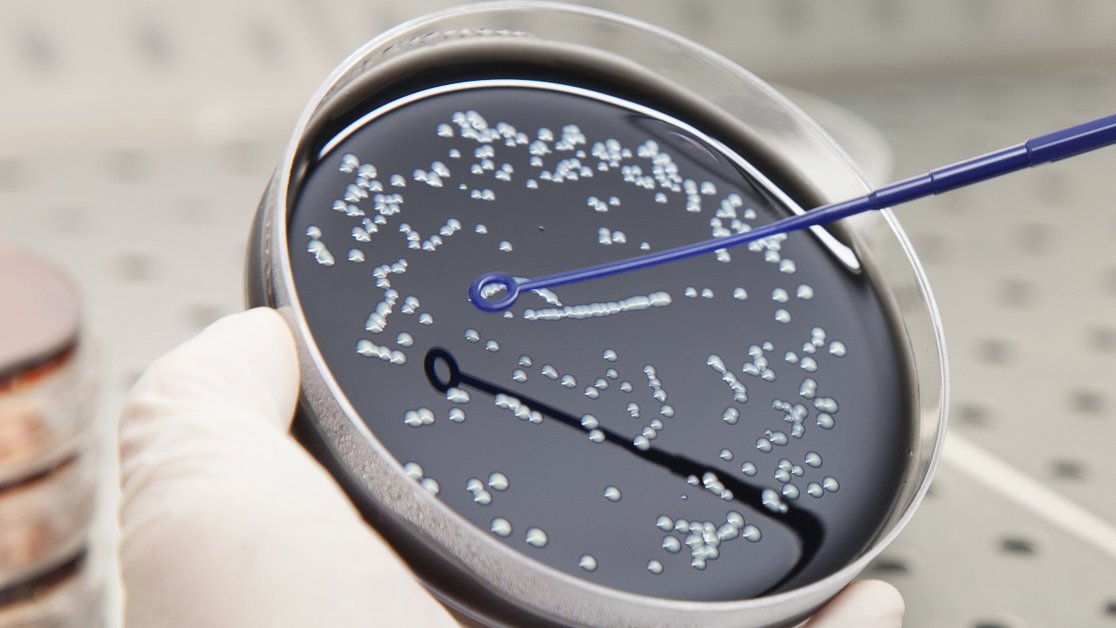

ETS-Testconsult Ltd (ETL) provides customers with a wide range of high quality and efficient testing services in the construction, engineering and associated industries, supported by totally unbiased and independent reporting.

Inspection
Environmental & Chemical

Calibration

Construction Materials

Structural Diagnostic & Instrumentation

Trading

We have a reputable and proven position of leadership in being the first to bring new technology and testing methods to an expanding range HOKLAS-approved tests and services. We continue to grow our services to meet and support our customers' requirements.
Highlights

2025.09.21
HOKLAS-Approved Updated Standards & Signatories
Following our most recent HOKLAS assessment in June 2025, three of our divisions were subsequently awarded updated standards. Additionally, our Waterworks Inspection division has nearly doubled the number of HKIAS-approved inspectors.
View More
2025.07.07
Flexible Pipe Joint Tests
We offer a range of flexible pipe joint tests to ensure that all inspections and tests are carried out within the specific parameters required by the contract.
View More
2025.06.20
ETL Awarded Two Year Housing Contract
ETL is proud to have been awarded a two year contract by the Hong Kong Housing Authority for the Non-Destructive Pile Testing for Foundation and Building Contracts.
View More






